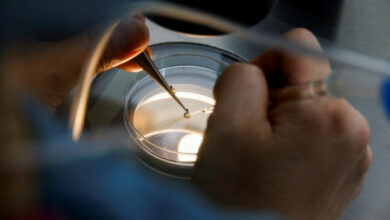
Singapur lockert die Regeln für das Einfrieren von Eizellen, da die Geburtenrate einen Rekordtiefstand erreicht hat

Welt News
Die wichtigsten politischen Entwicklungen, wirtschaftlichen Veränderungen, kulturellen Ereignisse und Umweltthemen. Unsere erfahrenen Reporter recherchieren und verfolgen die Geschehnisse der Welt.
-
US-Sonderermittler kritisiert FBI-Untersuchung zu Absprachen zwischen Trump und Russland
WASHINGTON – Die FBI-Untersuchung zu angeblichen Absprachen zwischen Russland und Donald Trumps Präsidentschaftswahlkampf 2016 basierte auf fadenscheinigen Beweisen und war ernsthaft fehlerhaft, sagte ein unabhängiger US-Staatsanwalt in einem am Montag veröffentlichten Bericht. Sonderermittler John Durham wurde 2019 vom Generalstaatsanwalt des damaligen Präsidenten Trump, Bill Barr, ernannt, um sich mit den…
-
Singapur lockert die Regeln für das Einfrieren von Eizellen, da die Geburtenrate einen Rekordtiefstand erreicht hat
Singapur wird die Regeln für das Einfrieren von Eizellen weiter lockern, indem es die Altersgrenze für Frauen erhöht, die sich dem Eingriff unterziehen möchten. Durch den am Montag vom Gesundheitsministerium und dem Ministerium für soziale und familiäre Entwicklung des Stadtstaats angekündigten Schritt wird die Altersobergrenze für das optionale Verfahren ab…
-
Das Wahlgremium in Kambodscha schließt die einzige Oppositionspartei von den Wahlen im Juli aus
PHNOM PENH: Kambodschas Wahlkommission hat am Montag die einzige oppositionelle Candlelight Party von der Teilnahme an den Wahlen im Juli ausgeschlossen, weil sie keine ordnungsgemäßen Registrierungsunterlagen vorgelegt hatte. Die Partei erklärte später, sie werde beim Verfassungsorgan des Landes Berufung gegen die Entscheidung einlegen. Andere Parteien haben sich für die Parlamentswahl…
-
Erdogans Aufstieg, während die Türkei auf eine historische Stichwahl zusteuert
ISTANBUL: Die Türkei ist am Montag mit der Aussicht auf ihre erste Stichwahl um das Präsidentenamt aufgewacht, nachdem der konservative Präsident Recep Tayyip Erdogan die Meinungsforscher und seinen säkularen Rivalen verblüfft und die erste Runde der entscheidenden Wahlen des Landes gewonnen hat. Meinungsumfragen vor der Wahl deuteten darauf hin, dass…
-
Die Ukraine begrüßt Bachmuts Erfolge als Selenskyj bei einem Besuch in Großbritannien
KIEW, Ukraine: Die Ukraine begrüßte am Montag ihre Fortschritte an der Frontlinie Bakhmut und Präsident Wolodymyr Selenskyj traf in London ein, um neue Hilfe zu erbitten, da die Erwartungen an eine Frühjahrsoffensive wuchsen. Im Vorfeld von Selenskyjs Gesprächen mit Premierminister Rishi Sunak sagte Großbritannien „Hunderte“ sowohl Luftverteidigungsraketen als auch Langstrecken-Angriffsdrohnen…
-
Malaysia will den Besitz und Konsum kleiner Mengen Drogen entkriminalisieren
KUALA LUMPUR: Malaysia will ein Gesetz einführen, um den Besitz und Konsum kleiner Mengen illegaler Drogen zu entkriminalisieren, sagte sein Innenminister am Montag und verwies auf die Notwendigkeit, die Überfüllung der Gefängnisse zu reduzieren. Der Schritt ist der jüngste in einer Reihe von Reformen der Strafjustiz, die von der Regierung…
-
Einen Monat nach Beginn des brutalen Krieges im Sudan ist kein Ende in Sicht
KHARTUM: Einen Monat nach Ausbruch des Konflikts im Sudan ist die Hauptstadt ein trostloses Kriegsgebiet, in dem sich terrorisierte Familien in ihren Häusern zusammendrängen, während in den staubigen, verlassenen Straßen draußen Schießereien toben. In ganz Khartum bleiben die noch Lebenden verbarrikadiert, in der Hoffnung, verirrten Kugeln zu entgehen und unter…
-
Die Thailänder stimmen mit überwältigender Mehrheit für Demokratieparteien, lehnen das Militär ab
Die Wahlergebnisse zeigten am Montag, dass die Wähler eine klare Ablehnung der fast zehnjährigen Militärherrschaft zum Ausdruck brachten und zwei demokratiefreundliche Oppositionsparteien unterstützten. Die Move Forward Party (MFP), die neueste Kraft in der thailändischen Politik, die die Energie der von Jugendlichen geführten Demokratieproteste im Jahr 2020 bündelte, sicherte sich die…
-
Unzerbrechliche Verteidigung, Lewandowskis schneller Start: Wie Barca La Liga gewann
BARCELONA – Barcelona hat sich am Sonntag zum ersten Mal seit 2019 den spanischen La Liga-Titel gesichert. Die katalanischen Giganten haben im vergangenen Sommer viel investiert und auf künftige Einnahmen geopfert, um den Kader zu stärken und schnell große Trophäen zu ergattern. Die Mannschaft von Xavi Hernandez gewann im Januar…
-
Lukaku ist zurück in Bestform, als Inter das Champions-League-Finale ins Auge fasst
MAILAND – Die Rückkehr von Romelu Lukaku zu glänzender Form hat Inter Mailand eine zusätzliche Waffe vor dem Halbfinal-Entscheidungsspiel der Champions League am Dienstag gegen den AC Mailand gegeben. Lukaku war die meiste Zeit der Saison verletzungsbedingt ausgefallen und hatte nach einer desaströsen Weltmeisterschaft einen beschädigten Ruf. Er hat sich…
-
Der Waffenstillstand im Gazastreifen hält weitgehend an, da Palästinenser und Israelis tödliche Folgen einkalkulieren
GAZA-STADT (PALÄSTINENSISCHE GEBIETE) – Am Sonntag kehrte Ruhe in Gaza ein, da ein fragiler Waffenstillstand weitgehend gehalten wurde und Palästinenser und Israelis die Kosten für fünf Tage grenzüberschreitenden Feuers tragen mussten, bei dem Dutzende Menschen ums Leben kamen. Die Fischer bestiegen ihre Boote in der palästinensischen Küstenenklave, als die Bewohner…
-
Biden ist hinsichtlich der Schuldengespräche mit den Republikanern „optimistisch“, da sich ein Zahlungsausfall abzeichnet
WASHINGTON – Präsident Joe Biden sagte am Sonntag, er bleibe „optimistisch“, eine Einigung mit seinen republikanischen Gegnern zu erzielen, um die US-Schuldengrenze anzuheben und einen Zahlungsausfall zu vermeiden, von dem seine Regierung warnte, dass er „katastrophale“ Folgen haben würde. Die Republikaner im Kongress fordern Haushaltskürzungen als Gegenleistung für die Aufhebung…
-
Erdogan vs. Kilicdaroglu: Zwei Visionen für die Zukunft der Türkei
ISTANBUL – Man akzeptiert das Chaos und verherrlicht die islamische Vergangenheit der Türkei. Der andere verspricht dem tief gespaltenen Land eine etwas ruhigere und wohlhabendere Zukunft. Die Wähler beschlossen, Präsident Recep Tayyip Erdogan und seinem Rivalen Kemal Kilicdaroglu am Sonntag eine weitere Chance zu geben, sie davon zu überzeugen, welche…
-
Man City steht kurz vor dem Titel, nachdem Arsenal gegen Brighton gerockt hat
LONDON – Manchester City steht kurz vor dem Gewinn des Premier-League-Titels, nachdem Arsenal am Sonntag gegen Brighton eine überraschende 0:3-Niederlage hinnehmen musste. Die Mannschaft von Mikel Arteta wurde im Emirates Stadium von den Toren von Julio Enciso, Deniz Undav und Pervis Estupinan in der zweiten Halbzeit erschüttert. Der Zweitplatzierte Arsenal…
-
Erdbebenstadt in der Türkei wird „nicht wieder für Erdogan stimmen“
ANTAKYA, Türkei: „Wir brauchen Veränderungen, wir haben genug“, sagte Mehmet Topaloglu, einer der ersten, der am Sonntag in der südtürkischen Stadt Antakya, die durch das diesjährige verheerende Erdbeben zerstört wurde, seine Stimme abgab. Für Topaloglu haben das Erdbeben der Stärke 7,8 im Februar, bei dem in der Türkei mehr als…
-
Selenskyj trifft in Deutschland ein, während die Ukraine eine Gegenoffensive vorbereitet
BERLIN: Der ukrainische Präsident Wolodymyr Selenskyj führte am Sonntag zu Beginn seines ersten Besuchs in Deutschland seit der russischen Invasion Gespräche mit seinem deutschen Amtskollegen, wobei Berlin nachdrückliche Unterstützung in Form eines riesigen neuen Militärpakets anbot. „Bereits in Berlin“, schrieb Selenskyj auf Twitter. „Waffen. Kraftvolles Paket. Luftverteidigung. Wiederaufbau. EU. NATO.…
-
Rekordtemperaturen, Hitzschlagfälle überschwemmen Südostasien
Südostasien hat weiterhin mit glühender Hitze zu kämpfen, da Rekordtemperaturen und Fälle von Hitzschlägen gemeldet werden, die die Anzeichen extremer Wetterveränderungen zusätzlich verstärken. Thailand stellte am 15. April einen neuen Rekord auf, als in der Provinz Tak 44,6 °C Quecksilber gemessen wurden. Singapur verzeichnete am Samstag mit 37 °C (98,6…
-
Die Philippinen setzen Bojen in Teilen des Südchinesischen Meeres, um ihre Souveränität zu behaupten
MANILA: Die Philippinen haben in ihrer ausschließlichen Wirtschaftszone (AWZ) Navigationsbojen platziert, um die Souveränität über die umstrittenen Spratly-Inseln im Südchinesischen Meer zu behaupten, sagte ein Sprecher der Küstenwache am Sonntag. Der Schritt erfolgt inmitten der zunehmend aggressiven Aktionen Chinas im Südchinesischen Meer, da der philippinische Präsident Ferdinand Marcos Jr. engere…
-
Mächtiger Zyklon rast auf Myanmar, Bangladesch zu; 400.000 evakuiert
DHAKA: Ein starker Sturm hat am Sonntag die Küsten Bangladeschs und Myanmars erfasst und Hunderttausende Menschen zur Evakuierung an sicherere Orte gezwungen, viele davon aus gefährdeten Häusern in tiefer gelegenen Gebieten. Zyklon Mocha, der Windgeschwindigkeiten von bis zu 210 km/h (130 mph) erzeugt, könnte Meereswellen von bis zu 4 Metern…
-
Die Temperatur in Singapur steigt auf 37 °C, den höchsten Wert seit vier Jahrzehnten
Die ohnehin schon dampfende Hitze in Singapur erreichte am Samstag erneut einen 40-Jahres-Rekord und stieg auf 37 °C (98,6 °F). Laut einer Erklärung der National Environment Agency auf Facebook war die Temperatur in Ang Mo Kio im Zentrum Singapurs mit einem Rekord im nahegelegenen Tengah im April 1983 vergleichbar. Singapur…